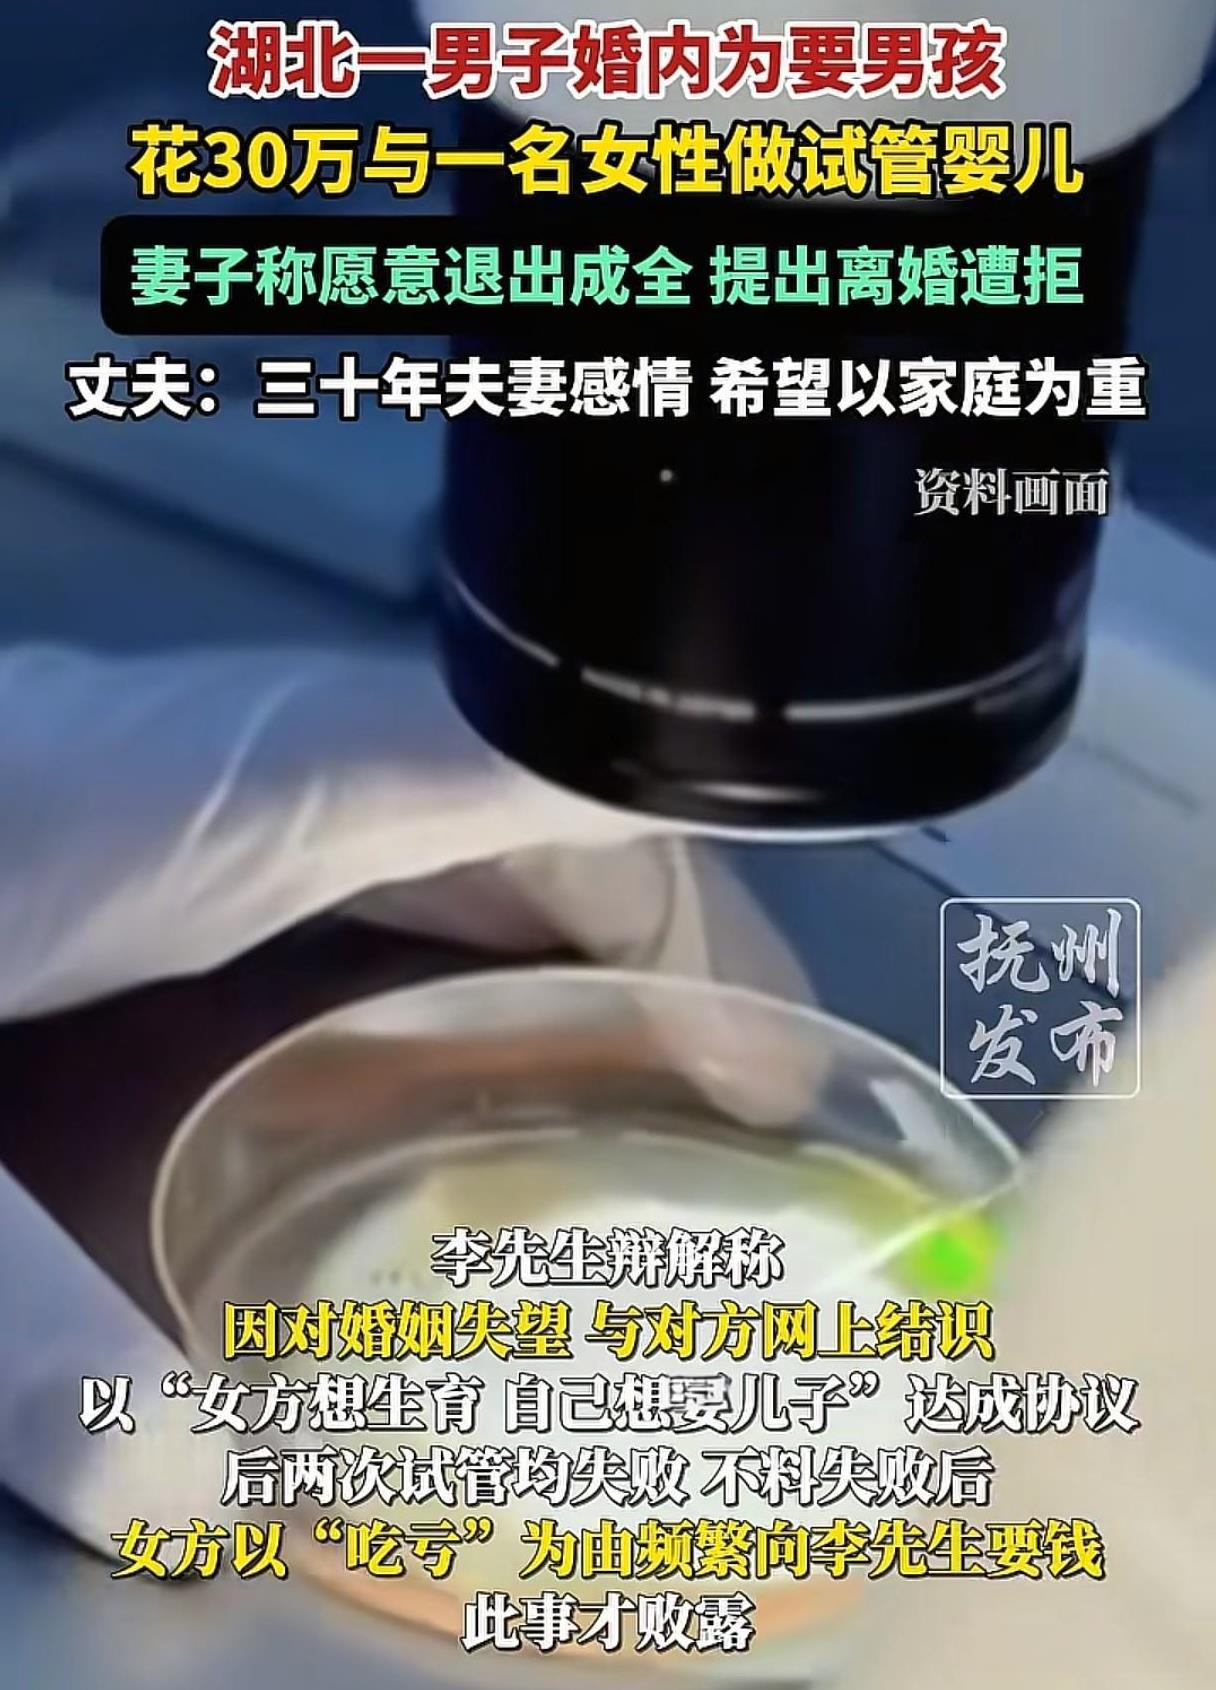

湖北,男子一直都想生一个儿子,可他和妻子结婚30年,都未能如愿,他遇到一个女子,两人一拍即合,做了两次试管,花了30多万,结果都失败了。女子觉得自己吃亏了,屡次问他要钱,事情败露,男人妻子气坏了,提出如果两人是真爱,她愿意离婚,成全两人,可男子的决定,让人有些看不懂。 王女士和李先生曾经是同事,王女士性格内向,平时总是安安静静的,可李先生性格开朗,走到哪里都是一片欢声笑语。 正是因为性格上的互补,两人在相处中渐生情愫,最终走到了一起。 婚后,夫妻二人开了一家餐馆,在两人的共同经营下,餐馆的生意一直都不错,一家人的日子过得红红火火的。 虽然两人衣食无忧,但是夫妻之间的小矛盾却不断,也许是未能生育一个男孩,李先生经常因为小事对王女士进行责怪辱骂,王女士既要帮着丈夫经营餐馆,又要照顾孩子和打理家里的一切大小事。 她原本想着,只要自己做到位了,那这个家就守住了。 可让她始料未及的是,2023年5月,她像往常一样在餐馆忙碌,却发现丈夫总是背着自己出去接听电话。 看过丈夫的手机后,她整个人都懵了,丈夫一向节俭,但是他却背着自己,花了30多万,和一名女子去做了2次试管婴儿。 王女士的手颤抖着,眼泪止不住地流,她怎么也想不明白,自己为这个家付出了这么多,丈夫怎么能做出这样的事情来? 她怒气冲冲地找到丈夫,质问他为何要这样做? 面对妻子的质问,李先生却解释说自己对这段婚姻失望透顶了。 闲来无事,他在网上聊天时,遇到了一名女子,对方想要生个孩子,自己又特别想要一个男孩,两人一拍即合,达成了协议,去做试管婴儿。 王女士听着丈夫的话,气愤难平,丈夫竟然如此轻易地就背叛了他们的婚姻,还把责任推得一干二净。 她强忍着心中的悲痛,表示既然丈夫觉得家庭生活不幸福,如果他和对方是真爱,她愿意离婚退出,成全两人。 李先生听到妻子要离婚,也慌了神,百般恳请,说自己会以家庭为重,说什么都不肯离婚。 王女士看着眼前这个曾经深爱的男人,此刻如此狼狈的恳请自己,心里五味杂陈,她不知道该不该相信他的话,这么多年的感情,不是说放下就能放下的。 可丈夫的背叛,让她陷入了深深的痛苦和挣扎之中。 目前,她尚未决定是否原谅丈夫、维系这段婚姻。 《民法典》第1043条规定:夫妻应当互相忠实,互相尊重,互相关爱。 夫妻之间有相互忠诚的义务,李先生背着妻子,和一女子进行试管婴儿的行为,严重违背了夫妻忠实的义务,也伤害了夫妻感情,这种行为既不道德,也违背了公序良俗。 李先生为了做试管婴儿,花费了30多万元,这笔钱属于夫妻共同财产。 夫妻对共同财产享有平等的处理权,在处理共同财产时,应当协商一致。 李先生在没有与王女士商量的情况下,擅自将大量夫妻共同财产用于与家庭共同生活无关的事项,如王女士起诉离婚,是可以要求对方进行合理的补偿的。 《民法典》第1092条规定:夫妻一方隐藏、转移、变卖、毁损、挥霍夫妻共同财产,或者伪造夫妻共同债务企图侵占另一方财产的,在离婚分割夫妻共同财产时,对该方可以少分或者不分。 如李先生将夫妻共同财产进行挥霍等,王女士如果提出离婚,是可以要求对方少分或者不分夫妻共同财产的。 如夫妻一方婚后出现严重伤害夫妻感情,并导致婚姻破裂的,另一方可以起诉离婚,并要求给予精神损害赔偿。 《民法典》第1091条规定,以下情形属于法定过错,无过错方可以在离婚时要求损害赔偿:重婚;与他人同居;实施家庭暴力;虐待、遗弃家庭成员;有其他重大过错。 李先生跟他人试管,属于有其他重大过错的行为,如王女士起诉离婚,是可以要求其给予精神损害赔偿的。 夫妻之间需要相互理解,相互关爱,当婚姻出现问题,应当跟对方好好沟通,开诚布公的去谈一谈,而不是采取背叛或者伤害对方的行为。 若存在代孕行为,则可能构成违法,需承担法律责任。 信源:抚州发布 2025年9月15日 关注@律觀法说 ,从法律角度看世界,感受不一样的人情冷暖。